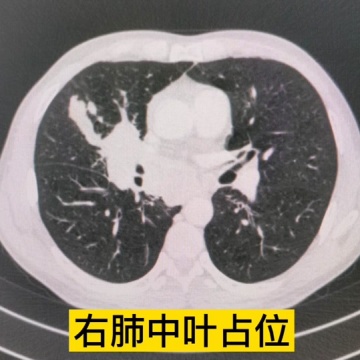
小细胞肺癌

小细胞肺癌(Small Cell Lung Cancer,SCLC)是重要的肺癌亚型,大约占肺癌(Lang Cancer,LC)的15%。一般认为SCLC起源于支气管黏膜或腺上皮内的嗜银细胞,属神经内分泌肿瘤,常见病因包括吸烟、环境污染和职业因素等环境因素和遗传因素等。全球每年新发SCLC约有25万例,死亡病例至少20万例。SCLC与吸烟密切相关,尽管SCLC对初始治疗敏感,但很快复发耐药,且复发后缺少有效治疗手段,预后差,是难治性肿瘤。SCLC可由原发病灶引起咳嗽、气促、咯血、胸痛、声嘶、饮水呛咳、上腔静脉综合征,转移到脑、肝、骨等器官后引起相应症状,如头痛、腹胀等,还可有肿瘤伴发综合征。SCLC的预防应采取三级预防模式,包括病因预防的一级预防、早发现、早诊断和早治疗的二级预防,又称为“三早预防”,和在疾病的临床期减少疾病的危害的三级预防。SCLC的治疗包括手术治疗、药物治疗、放射治疗和介入治疗。SCLC是肺癌中对放疗最敏感的类型,同时对化疗十分敏感,化疗为治疗的基本方案。90%以上的SCLC就诊时已经有远处转移,一般不推荐手术治疗。1789年Martin Klaproth发现铀后,欧洲矿工在捷克开采沥青铀矿,在这群矿工上患有一种奇特的病,称为“矿工病”,到1879年确定矿工的死因是肺癌,后来的研究说明大多数矿工患的是SCLC。